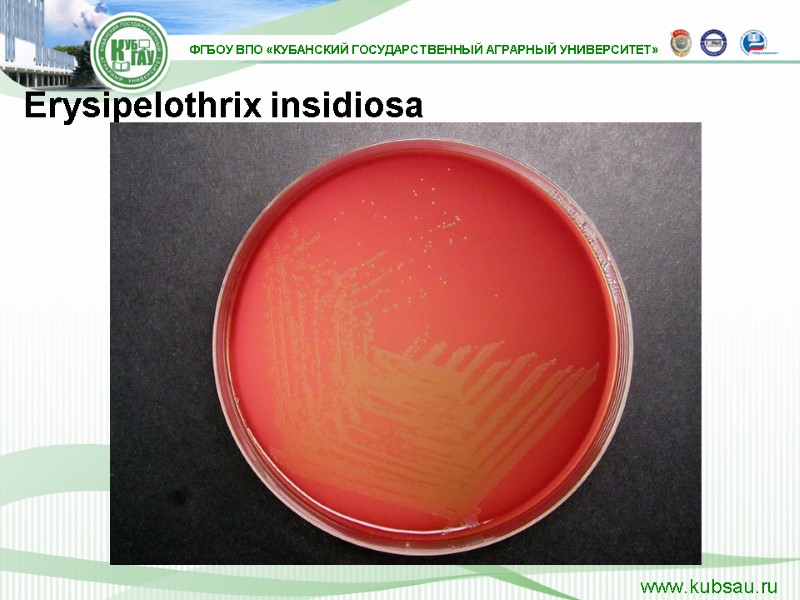
Erysipelothrix insidiosa
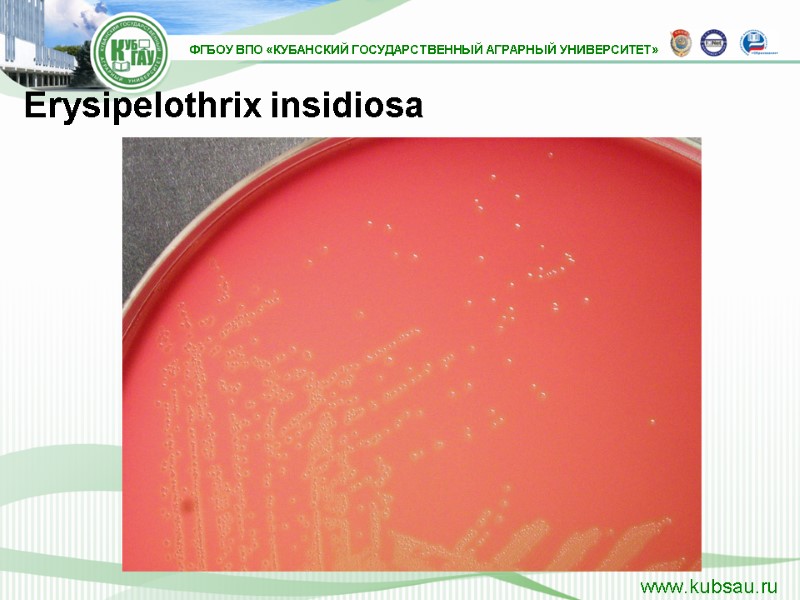
Erysipelothrix insidiosa
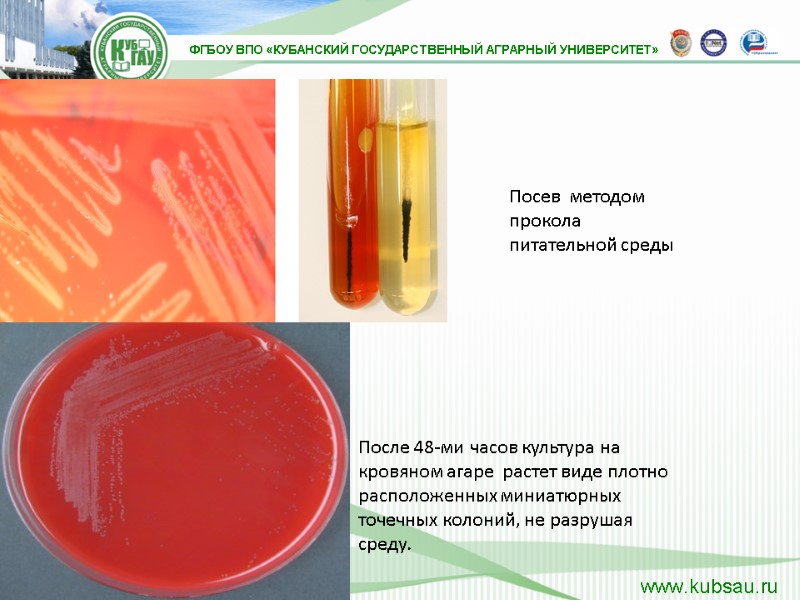
После 48-ми часов культура на кровяном агаре  растет виде плотно расположенных миниатюрных точечных
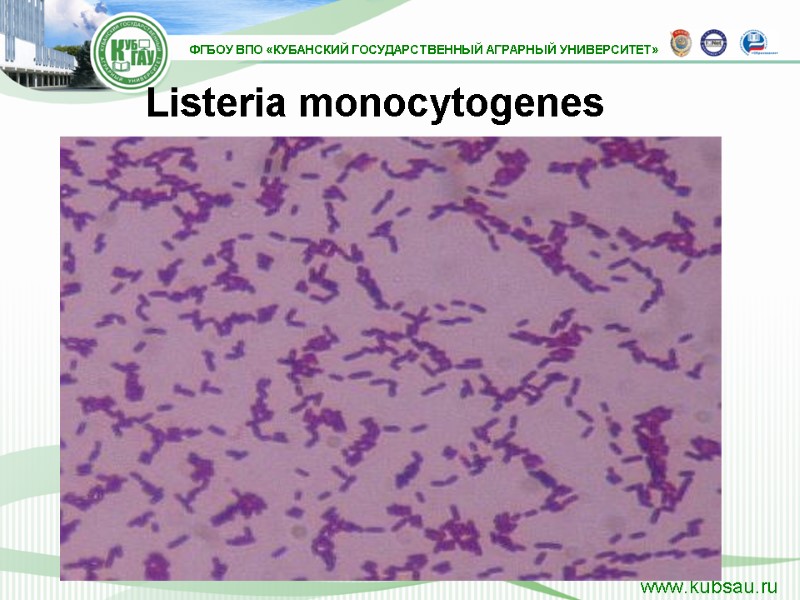
Listeria monocytogenes

КАФЕДРА МИКРОБИОЛОГИИ, ЭПИЗООТОЛОГИИ И ВИРУСОЛОГИИ Ведущий преподаватель доктор


КАФЕДРА МИКРОБИОЛОГИИ, ЭПИЗООТОЛОГИИ И ВИРУСОЛОГИИ Ведущий преподаватель доктор биологических наук, профессор Нино Нодариевна Гугушвили

Ветеринарная Микробиология Дисциплина:

Лабораторные занятия по частной микробиологии для факультета ветеринарной медицины

Возбудители рожи свиней и листериоза Тема

План занятия: 1. Изучить правила отбора диагностического материала для исследования на рожу свиней и листериоз. 2. Изучить морфологию возбудителей по наглядным пособиям и препаратам. 3. Изучить, зарисовать схему лабораторной диагностики рожи свиней и листериоза, описать. 4. Изучить культуральные свойства возбудителей демонстрационных культурах, записать, зарисовать. 5. Приготовить из культуры возбудителя мазок, окрасить, промикроскопировать, зарисовать. 6. Ознакомиться с биопрепаратами применяемыми при роже свиней и листериозе.

Рожа свиней (Erysipelas suum) Инфекционная болезнь, поражающая свиней преимущественно в возрасте от 3 до 12 месяцев, протекающая остро, с явлениями септицемии и хронически – с симптомами эндокардита, серофибринозного полиартрита или некрозов кожи. Болеет и человек. Возбудителя рожи впервые открыли Пастер и Тюйе (1882).

Возбудитель – Erysipelothrix insidiosa (rhusiopathiae) Г+ С- К- П-

Возбудитель – Erysipelothrix insidiosa (rhusiopathiae) относится к роду Erysipelothrix. Факультативный анаэроб, Грам положительная палочка, спор и капсул не образует, неподвижная, в мазках – в виде тонких нитей, размером 0,2–0,3 х 0,8–2,5 мкм. В старых бульонных культурах представляет собой удлинённые и нитевидные палочковидные формы.

Erysipelothrix insidiosa (rhusiopathiae)

Erysipelothrix insidiosa (rhusiopathiae)

Культивирование. Бактерия растёт в аэробных и анаэробных условиях, лучше в атмосфере с пониженным давлением кислорода и содержащей 5–10% двуокиси углерода (микроаэрофил). Культивируется на МПА, МПЖ, в МПБ, бульоне Хоттингера, элективной среде Сент-Иваньи (агаровая среда с 0,1% кристалвиолета и 1% азида натрия). Хорошо растёт при 36–37°С, рН 7,2–7,6.

На МПА – растёт в виде мелких росинчатых просвечивающихся колоний (S-форма), трудно различимых невооружённым глазом. Бактерии в S-форме выделяются при септицемии. При хроническом течении болезни образуются колонии R-формы – крупные, с неровной волокнистой поверхностью и отходящими от края корнеобразными отростками.

В МПБ растёт в виде слабого помутнения среды без образования пристеночного кольца и плёнки, при встряхивании пробирки видны муаровые волны. Через 48–72 ч среда просветляется, на дне пробирки формируется незначительный осадок, при встряхивании поднимается в виде облачка. В столбике желатина при посеве уколом через 6–10 дней появляются серовато-белого стержня горизонтальные нежные отростки, желатин не разжижается.
Erysipelothrix insidiosa

Erysipelothrix insidiosa
Erysipelothrix insidiosa

1. ОБНАРУЖЕНИЕ ВОЗБУДИТЕЛЯ в исходном материале методом световой микроскопии; 2. ВЫДЕЛЕНИЕ ЧИСТОЙ КУЛЬТУРЫ посевом на питательные среды или методом биопробы; 3. ИДЕНТИФИКАЦИЮ ВОЗБУДИТЕЛЯ по культурально-морфологическим, ферментативным, серологическим и патогенным признакам (методом биопробы). Бактериологическое исследование включает в себя:

Биохимические свойства Возбудитель рожи свиней выделяет сероводород, не образует индол и каталазу; большинство штаммов ферментируют с образованием кислоты без выделения газа лактозу, глюкозу, галактозу, левулёзу, в слабой степени – ксилозу, редко арабинозу, мальтозу и рамнозу, не ферментируют сахарозу, маннит и салицин.

Диагностика и дифференциальная диагностика В лабораторию направляют труп животного целиком или паренхиматозные органы, трубчатую кость; при подозрении на хроническое течение – сердце. В лаборатории проводят микроскопию, бактериологическое и серологическое исследования РА, метод флюоресцирующих антител.

Микроскопия. Делают мазки-отпечатки из органов и окрашивают по Граму. В мазках обнаруживают грамположительные палочки, расположенные одиночно, попарно или скоплениями, при хроническом течении – длинные переплетающиеся нити. Посев на питательные среды делают из крови сердца, поражённых клапанов, почки, селезёнки, печени, костного мозга в МПБ или бульон Хоттингера и на МПА.

Посевы инкубируют при температуре 36–37°С в течение 18–24 ч., при отсутствии роста выдерживают ещё сутки. Полученную выращенную культуру идентифицируют по морфологическим, тинкториальным, культуральным и биохимическим свойствам, а также в реакции агглютинации с позитивной (положительной) специфической сывороткой.

Подвижность определяют посевом в полужидкий агар, биохимическую активность – на средах Гисса с глюкозой, лактозой, сахарозой и маннитом, определяют образование сероводорода и каталазы.

РА ставят с гипериммунной лечебной сывороткой на предметном стекле. Для этого наносят каплю сыворотки в разведении 1:50, затем бактериальной петлёй суточную агаровую культуру тщательно растирают. В положительном случае агглютинация наступает быстро, агглютинат имеет вид плотных мелких комочков.

Культура рожи свиней не обладает подвижностью, выделяет сероводород, не образует каталазу, разлагает глюкозу, лактозу (без газа), не ферментирует сахарозу и маннит, даёт положительную РА. В патологическом материале бактерии рожи обнаруживают методом флюоресцирующих антител.

Биопроба. Заражают 10% суспензией из органов или бульонной культурой белых мышей или голубей, подкожно по 0,1–0,2 мл, голубей внутримышечно. Животные погибают через 2–4 суток после заражения. Из органов павших мышей и голубей делают посев в МПБ и на МПА для выделения чистой культуры возбудителя.

Рожу следует отличить от чумы свиней и пастереллеза. При чуме поражается толстый отдел кишечника, а при роже – тонкий отдел. При чуме лимфоузлы имеют мраморный рисунок. При пастереллезе характерные изменения в легких.


Отдельные очаги локализации возбудителя при крапивной форме рожи






Рожистые пятна на коже свиньи

Ромбовидные красные пятна и очаги омертвения кожи свиньи при роже свиньи

Острый бородавчатый эндокардит при роже свиньи

Катарально-геморрагическое воспаление желудка и двенадцатиперстной кишки при роже свиньи

Гиперемия и кровоизлияния в почке при роже свиньи

Артрит, после воздействия на сустав Erysipelothrix rhusiopathiae , обратите внимание на гипперемию, и увеличение синовиальной ткани.

Некроз кожи при буллезно-геморрагической роже.

Эритематозно-геморрагическая рожа нижней конечности.

После 48-ми часов культура на кровяном агаре растет виде плотно расположенных миниатюрных точечных колоний, не разрушая среду. Посев методом прокола питательной среды

Иммунитет и биопрепараты Переболевшие свиньи приобретают стойкий и длительный иммунитет. После вакцинации активный иммунитет продолжается до 6 мес., пассивный до 2 недель. Впервые профилактические прививки применил Л.Пастер (1883) против рожи аттенуированными культурами. В России впервые живые вакцины против рожи свиней получили П.И.Боровский (1897) и Д.Ф. Конев (1904). В нашей стране применяют концентрированную гидроокисьалюминиевую формол-вакцину против рожи свиней и вакцину против рожи свиней из штамма ВР-2.

Для пассивной профилактики и лечения больных животных используют гипериммунную сыворотку. Для терапии применяют антибиотики: пенициллин, стрептомицин, эритромицин, окситетрациклин, нитрофурановые препараты. Пенициллин вводят в дозе 2–3 тыс. ЕД/кг с интервалом в 6-8 ч. Лучшие результаты получены при совместном введении сыворотки с антибиотиками.

Клинически здоровых животных пассивно иммунизируют противорожистой сывороткой, а через 10–12 дней вакцинируют. Вакцинацию можно проводить и без предшествующей пассивной иммунизации, но в этом случае необходимо в течение 7–10 дней наблюдать за привитым поголовьем, чтобы своевременно выявить больных свиней, привитых в инкубационном периоде.

На неблагополучные хозяйства или отдельные фермы накладывают карантин, который снимают через 14 дней после последнего случая выздоровления или падежа больного животного и проведения заключительной очистки и дезинфекции помещений, предметов ухода и т. п.

Вынужденный убой больных свиней необходимо проводить в специально отведенном месте. Мясо от убитых животных допускается в пищу только после проварки. После каждого случая заболевания рожей помещения, где находились больные свиньи, подлежат тщательной очистке и дезинфекции.

Санитарная оценка продуктов убоя животных Туши и субпродукты, полученные от свиней, больных или подозреваемых в заболевании, в сыром виде не выпускают. При наличии дегенеративных изменений в мускулатуре все внутренние органы и туши направляют на техническую утилизацию. При отсутствии патологоанатомических изменений в туше и во внутренних органах проводят бактериологическое исследование на сальмонеллы. В случае обнаружения сальмонелл внутренние органы направляют на утилизацию, а тушу – на проварку. При отсутствии сальмонелл тушу, шпик и внутренние органы перерабатывают на колбасы. Пораженные внутренние органы, кишки, кровь направляют на утилизацию.

Для дезинфекции помещения и места убоя подвергают обработке осветленным раствором хлорной извести с 3% активного хлора, 2%-ным раствором едкого натра (70–80ºС), 0,5%-ным раствором формальдегида, 5%-ным раствором кальцинированной соды (70–80ºС) из расчета 1л/кв.м, экспозиция – 1 ч.

Листериоз (Listeriosis) Острая инфекционная болезнь млекопитающих и птиц, характеризующаяся поражением центральной нервной системы, абортами и маститами, септическими явлениями или протекающая в форме бессимптомного носительства. Болеет и человек.

По современной классификации листерии внесены в группу 19 (неспорообразующие грамположительные палочки правильной формы), род Listeria, в котором насчитывается 8 видов: L. monocytogenes, L. Ivanovii, L. innocua, L.seeligeri, L. welshimeri, L. grayi, L.murrayi, L. denitrificans.

Морфология L. mоnocytogenes – полиморфная палочка с закруглёнными концами, 0,5–2 мкм длины, 0,3–0,5 мкм ширины, подвижная, грамположительная, факультативно-аэробная. В мазках палочки располагаются одиночно, в виде римской цифры V или по нескольким параллелям. Спор и капсул не образуют.

Возбудитель: Listeria monocytogenes Г+ С- К- П+

Listeria monocytogenes

Listeria monocytogenes

Listeria monocytogenes
Listeria monocytogenes

Культивирование Листерии – факультативные аэробы, но растут и в анаэробных условиях. Оптимум температурного роста на питательных средах 36–38ºС с рН 7,2–7,4, однако они могут расти и при температуре от 4º до 45ºС. На МПА (2-3 день) растут мелкие, прозрачные росинчатые округлые колонии, становящиеся впоследствии мутными, с голубоватым оттенком. В МПБ вызывают помутнение среды с образованием слизистого осадка, поднимающегося при встряхивании в виде косички.

На печёночных средах (с добавлением 1% глюкозы и 2–3% глицерина) вырастают слизистые колонии . В качестве элективных сред используют МПБ с 0,05% теллурита калия или 0,01–0,02% теллурита калия в водном растворе глицерина и растворе флоримецина или полимиксина. На кровяном агаре вокруг колоний образуется узкая зона гемолиза.

Биохимические свойства Листерии ферментируют с образованием кислоты без газа глюкозу, декстрозу, рамнозу и салицин (ферментация салицина - важный момент в дифференциации листерии и рожистой палочки, которая не сбраживает салицин), трегалозу, левулёзу; замедленно - сахарозу, крахмал, глицерин, декстрин; некоторые культуры разлагают лактозу и мальтозу. Не ферментируют рафинозу, дульцит, инулин и сорбит; не образуют индол, сероводород и аммиак, не свертывается молоко;

не разжижают желатин, не восстанавливают нитраты в нитриты, дают положительную пробу на каталазу. Выделяют бета-гемолизин. Разлагают перекись водорода с выделением пузырьков кислорода. Редуцируют метиленовую синь.

Листерии

Listeria monocytogenes

Listeria monocytogenes

Диагностика и дифференциальная диагностика В лабораторию направляют трупы мелких животных или голову (головной мозг), печень, селезенку, лимфатические узлы, абортированный плод и его оболочки. Проводят микроскопические, бактериологические исследования, метод флюоресцирующих антител, серологические исследования (РА, РСК, РНГА), ставят биологическую пробу. Вначале проводят микроскопию мазков-отпечатков из патологического материала и окрашивают по Граму, а также методами флюоресцирующих антител.

Схема исследования при листериозе

Проводят посевы из органов и головного мозга на питательные среды, а также на кровяном агаре и селективные среды. Рекомендуется часть материала сохранять в холодильнике в течение 30 дней для проведения повторных исследований при отрицательном результате первичного посева. Посевы инкубируют в термостате при 37ºС с ежедневным просмотром в первые 3–4 дня. Если роста нет, то наблюдают в течение 2-х недель. Выделенные культуры исследуют на подвижность, изучают ферментативные свойства на средах Гисса, ставят пробу на каталазу и дифференцируют от возбудителя рожи свиней (делают посев на среду с метилротом или нетральротом в смеси с метиленовой синью). Листерии обесцвечивают среды, возбудитель рожи свиней не обесцвечивают.

Ставят капельную РА на стекле с поливалентной листериозной агглютинирующей сывороткой. Затем с помощью типовых (серогрупповых) сывороток определяют серотип (серогруппу) выделенной культуры. Специфические свойства листерий проверяют также конъюнктивальной пробой на морских свинках или внутрикожной пробой на морских свинках или кроликах.

Конъюнктивальная проба. На конъюнктиву глаза морской свинки наносят две капли испытуемой бульонной культуры с последующим лёгким массажем век ватным тампоном. На 2-4 день вирулентные листерии вызывают гнойный кератоконъюнктивит. При внутрикожной пробе через 48 ч возникает воспаление с последующим некрозом и образованием струпа. Для типирования культур используют также листериозные бактериофаги, включающие два монофага L2A и L4A.

Серологическая диагностика. Сыворотку животных используют в РА и РСК. Для РА применяют 2 антигена (первой и второй серогруппы), представляющие собой взвесь листерий, инактивированных кипячением. РА признаётся положительной с оценкой не менее, чем 2 креста в разведениях сыворотки 1:200 для овец, коз и свиней, 1:400 для лошадей и КРС, 1:50 для кроликов. РСК исследуют сыворотки крови в разведении 1:10 с использованием листериозного антигена.

Биологическая проба Используют белых мышей и кроликов. Заражают внутрибрюшинно или внутривенно в дозе 0,3–0,5 мл суточной культуры.

При постановке диагноза необходимо дифференцировать листериоз от рожи свиней, бешенства, болезни Ауески, злокачественной катаральной горячки, бруцеллеза, кампилобактериоза, трихомоноза, ценуроза (овец), кормовых отравлений.

Иммунитет и средства специфической профилактики Переболевшие животные приобретают относительный иммунитет. Для профилактики болезни применяют сухую живую вакцину из аттенуированного штамма АУФ листерий первого серотипа. После однократного её введения у КРС, свиней и овец создаётся иммунитет продолжительностью до одного года, у кроликов и норок – до 6 мес. Выпускают диагностические агглютинирующие сыворотки. Листериозные флуоресцирующие сыворотки. Листерии чувствительны к антибиотикам тетрациклинового ряда (окситетрациклин, хлортетрациклин) и ампициллину.

Лечение. Больных животных с признаками поражения центральной нервной системы направляют на убой. Остальных больных и подозрительных по заболеванию изолируют и лечат внутримышечным введением окситетрациклина, тетрациклина по 25–30 мг/кг массы животного 2–3 раза в сутки и других антибиотиков до снижения температуры тела. Эффективным является пероральное применение биомицина в дозе 25 мг, террамицина – 30 мг/кг массы животного 2–3 раза в сутки до понижения температуры тела. После снижения температуры тела до физиологической нормы рекомендуется применение пролонгированных препаратов — рифампицина и ампициллина (10 тыс. ед./кг 2 раза в сутки), неомицина (по 10–15 тыс. ед./кг 2 раза в сутки). Выбор антибиотиков определяют по антибиотикограмме. Применяют также сердечные, вяжущие средства, назначают диету.


Благодарю за внимание!
9206-lpz_5_rozha_sv_i_listerioz.ppt
- Количество слайдов: 77

